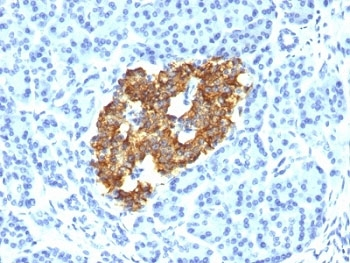
Insulin Antibody
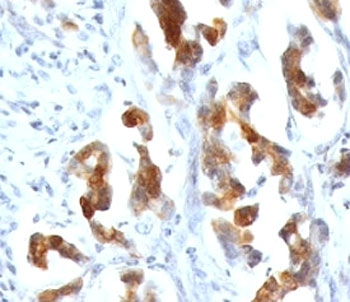
MUC5AC Antibody

You have no items in your shopping cart.
- Recombinant MART-1 Antibody / Rabbit Monoclonal [orb2642105]
IHC-P
Human
Rabbit
Recombinant
Unconjugated
7 ml - Recombinant Melan-A Antibody / Rabbit Monoclonal [orb2642108]
IHC-P
Human
Rabbit
Recombinant
Unconjugated
7 ml - Placental Alkaline Phosphatase Antibody [orb2638409]
IHC-P, WB
Human
Mouse
Monoclonal
Unconjugated
100 μg